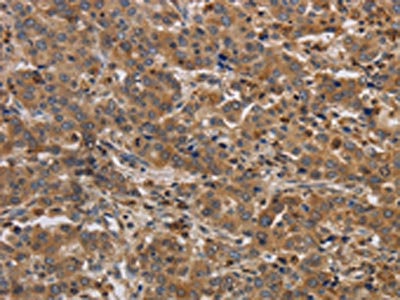

RAB22A Antibody
-
中文名稱:RAB22A兔多克隆抗體
-
貨號(hào):CSB-PA265650
-
規(guī)格:¥1100
-
圖片:
-
The image on the left is immunohistochemistry of paraffin-embedded Human liver cancer tissue using CSB-PA265650(RAB22A Antibody) at dilution 1/20, on the right is treated with synthetic peptide. (Original magnification: ×200)
-
Gel: 12%SDS-PAGE, Lysate: 40 μg, Lane: MCF7 cells, Primary antibody: CSB-PA265650(RAB22A Antibody) at dilution 1/650, Secondary antibody: Goat anti rabbit IgG at 1/8000 dilution, Exposure time: 30 seconds
-
-
其他:
產(chǎn)品詳情
-
Uniprot No.:
-
基因名:
-
別名:3732413A17Rik antibody; AI662177 antibody; AW319644 antibody; AW550514 antibody; E130120E14Rik antibody; GTP binding protein RAB22A antibody; MGC16770 antibody; OTTMUSP00000017605 antibody; Rab 22 antibody; RAB 22A antibody; Rab-22 antibody; Rab22 antibody; RAB22A antibody; RAB22A member RAS oncogene family antibody; Ras related protein Rab 22A antibody; Ras related protein Rab22A antibody; Ras-related protein Rab-22A antibody; RB22A_HUMAN antibody
-
宿主:Rabbit
-
反應(yīng)種屬:Human,Mouse
-
免疫原:Synthetic peptide of Human RAB22A
-
免疫原種屬:Homo sapiens (Human)
-
標(biāo)記方式:Non-conjugated
-
抗體亞型:IgG
-
純化方式:Antigen affinity purification
-
濃度:It differs from different batches. Please contact us to confirm it.
-
保存緩沖液:-20°C, pH7.4 PBS, 0.05% NaN3, 40% Glycerol
-
產(chǎn)品提供形式:Liquid
-
應(yīng)用范圍:ELISA,WB,IHC
-
推薦稀釋比:
Application Recommended Dilution ELISA 1:1000-1:5000 WB 1:500-1:2000 IHC 1:25-1:100 -
Protocols:
-
儲(chǔ)存條件:Upon receipt, store at -20°C or -80°C. Avoid repeated freeze.
-
貨期:Basically, we can dispatch the products out in 1-3 working days after receiving your orders. Delivery time maybe differs from different purchasing way or location, please kindly consult your local distributors for specific delivery time.
-
用途:For Research Use Only. Not for use in diagnostic or therapeutic procedures.
相關(guān)產(chǎn)品
靶點(diǎn)詳情
-
功能:Plays a role in endocytosis and intracellular protein transport. Mediates trafficking of TF from early endosomes to recycling endosomes. Required for NGF-mediated endocytosis of NTRK1, and subsequent neurite outgrowth. Binds GTP and GDP and has low GTPase activity. Alternates between a GTP-bound active form and a GDP-bound inactive form.
-
基因功能參考文獻(xiàn):
- RAB22A is significantly upregulated in melanoma, plays an oncogenic role in the malignant phenotypes of melanoma cells, and its expression in melanoma is regulated by epigenetical mechanism. PMID: 27690221
- that Rab22a enhances recycling of CD147, which is required for lung cancer cell migration and invasion PMID: 28433697
- Rab3A-22A blocks exocytosis at a stage downstream intra-acrosomal calcium release. PMID: 27613869
- RAB22A role in epithelial-mesenchymal transition of melanoma cells PMID: 27237979
- the HOTAIR lncRNA positively regulated the protein expression of Rab22a through competition for miR-373 binding. the positive regulation between HOTAIR and Rab22a may be partially attributed to the ceRNA regulatory network via miR-373, indicating a potential therapeutic target for ovarian cancer. PMID: 27484896
- miR-204 suppressed renal cell carcinoma proliferation and invasion by directly targeting the RAB22A gene. PMID: 26883716
- Data show that Rab22a- and Rab5a-driven phagosomal uptake is a crucial step in the vesicular cascade that leads to elimination of spirochetes by macrophages. PMID: 26344766
- our results demonstrated that miR-203 act as a tumor suppressor miRNA through regulating RAB22A expression and suggested its involvement in osteosarcoma progression and carcinogenesis. PMID: 26382657
- Vaccinia virus traffics to early endosomes, where recycling endosome markers Rab11 and Rab22 are recruited to participate in subsequent virus trafficking prior to virus core uncoating in the cytoplasm. PMID: 26041286
- these results demonstrate that miR-373 suppresses epithelial ovarian cancer invasion and metastasis by directly targeting Rab22a gene PMID: 25460499
- Re-expression of miR-193b in breast cancer cell lines decreased DNAJC13 (HPS40) and RAB22A expression, providing a mechanism by which mir193-b acts as a tumor suppressor. PMID: 25550792
- miR-204-5p acts as a tumor suppressor in colorectal cancer through inhibiting RAB22A and reveal RAB22A to be a new oncogene and prognostic factor for colorectal cancer. PMID: 25294901
- Exposure of human breast cancer cells to hypoxia augments microvesicle (MVs) shedding that is mediated by the HIF-dependent expression of the small GTPase RAB22A, which colocalizes with budding MVs at the cell surface. PMID: 24938788
- Data report the identification of Rab22 as a binding site on early endosomes for direct recruitment of Rabex-5 and activation of Rab5, establishing a Rab22-Rab5 signaling relay to promote early endosome fusion. PMID: 19759177
- Rab22a may regulate the dynamic interactions of endosomal compartments and it may be involved in the communication between the biosynthetic and early endocytic pathways. PMID: 11870209
- Rab22a regulates different steps in the recycling of cargo protein that has entered the cell independently of clathrin. PMID: 15181155
- Rab22a can affect the trafficking from endosomes to the Golgi apparatus probably by promoting fusion among endosomes and impairing the proper segregation of membrane domains required for targeting to the trans-Golgi network (TGN). PMID: 15748882
- Rab22a controls the transport of the transferrin receptor from sorting to recycling endosomes. PMID: 16537905
顯示更多
收起更多
-
亞細(xì)胞定位:Endosome membrane; Lipid-anchor. Cell membrane; Lipid-anchor. Early endosome. Late endosome. Cell projection, ruffle. Cytoplasmic vesicle. Cytoplasmic vesicle, phagosome. Cytoplasmic vesicle, phagosome membrane; Lipid-anchor; Cytoplasmic side.
-
蛋白家族:Small GTPase superfamily, Rab family
-
數(shù)據(jù)庫鏈接:
Most popular with customers
-
-
YWHAB Recombinant Monoclonal Antibody
Applications: ELISA, WB, IHC, IF, FC
Species Reactivity: Human, Mouse, Rat
-
Phospho-YAP1 (S127) Recombinant Monoclonal Antibody
Applications: ELISA, WB, IHC
Species Reactivity: Human
-
-
-
-
-